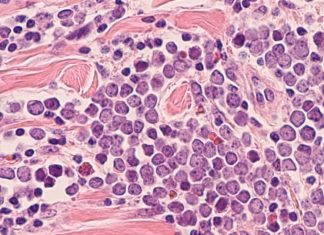
Ova vrsta izuzetno agresivnog karcinom javlja se najčešće kod ljudi preko 50 godina: Brzo se širi, a vrlo teško se otkriva, evo kako ga prepoznati

Isidora Bjelica, priznata spisateljica i istinska borkinja, preminula je 2016. godine nakon dugotrajne borbe s rakom, koju je uspešno prebrodila četiri puta.Na pitanje kako je ta borba uticala na nju i kako je okolina reagovala na njenu bolest, Isidora je izjavila: “Prošla sam kroz 12 zemalja i stotine terapija. Odlučila sam isprobati sve što postoji. Niko ne zna šta je kancer i kako nastaje. Ja sam jako otvorena osoba i kako bih bila duže sa decom, rešila sam da probam sve, ma koliko teško i bolno to bilo,” delila je za Bktvnews.com.
Isidora je u svojoj borbi sa opakom bolešću tražila ne samo fizički, već i duhovni odgovor: “Dosta sam naučila o ljubavi, životu, umu, telu. Menjala sam se i učila. Grešila, vraćala se, ispravljala pa ponovo, padala, menjala, probala… Verovala sam da Gospod mora biti milostiv prema nekom ko je toliko uporan i iskren u srcu.”
Nisu pušila, pila, niti se nezdravo hranila, a Isidora je isticala kako takve navike nisu uzrok njene bolesti. Uzrok je videla u duševnom stanju koje je osećala: “Nisam jela kobasice, slaninu, niti pušila cigarete, niti pila alkohol. Tuga je ta koja je najkancerogenija, a nje sam imala u galonima.”
Borba sa bolešću trajala je punih osam godina, ali svi teški momenti, mučne terapije i bolovi koje je osećala nisu pokolebali Isidoru u odluci da pobedi rak. Bila je optimista i delila je sa javnošću čak i najmanje detalje svoje borbe kroz mučne hemoterapije, s nadom da će pomoći onima koji prolaze kroz iste izazove.Nije prestala ni sa pisanjem, već je bolest bila dodatna inspiracija za pisanje nekoliko romana, u kojima je dotakla i temu svoje borbe. Osim raka, vodila je i finansijsku bitku jer su tretmani bili izuzetno skupi i većini, uključujući i nju, nedostupni.
Pevač Vlado Georgiev je 2015. godine organizovao seriju koncerata i uspeo je skupiti 15.000 evra, neophodnih Isidori Bjelici za prvu turu terapija u Švajcarskoj. Ova humanitarna gesta privukla je mnoge koji su želeli pomoći poznatoj spisateljici u njenoj borbi s teškom bolešću. Isidora, iako u borbi s opakom bolešću, zadržala je svoj duh i smisao za humor, ističući kako je “rak najgora sponzoruša, troši bez prestanka.”